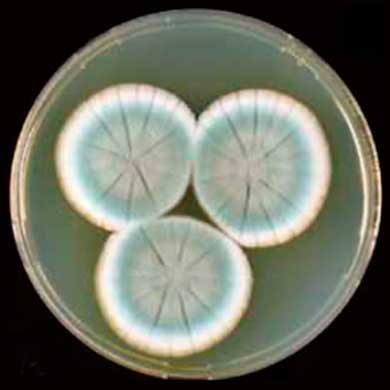
Пеницилл

Александр Флеминг

Александр Флеминг на марке Гвинея-Бисау (Западная Африка)
Серия: Личности 20-ого столетия.
Серия: Личности 20-ого столетия.
На марке изображен:
Александр Флеминг (06.08.1881 — 11.03.1955) - британский бактериолог,
который в 1928 гогу открыл пенициллин из плесневых грибов Penicillium notatum — первый антибиотик (противомикробный препарат). Грибы на марке:
- Подосиновик жёлто-бурый, или красно-бурый (Leccinum versipelle)
- Маслёнок зернистый или маслёнок летний (Suillus granulatus)
- Белый гриб или боровик (Boletus edulis)
- Сыроежка болотная или поплавуха (Russula paludosa)

140 лет со дня рождения Александра Флеминга
(Марка, Центральная Африка, 2021 год)
Грибы Penicillium rubens (вид несовершенных грибов) в чашке Петри
(Марка, Центральная Африка, 2021 год)
Изображены грибы:
Пеницилл (Penicillium rubens) в чашке Петри,
Лисичка обыкновенная (Cantharellus cibarius),
Белый гриб (Boletus edulis).
Пеницилл (Penicillium rubens) в чашке Петри,
Лисичка обыкновенная (Cantharellus cibarius),
Белый гриб (Boletus edulis).
Грибы Penicillium rubens (вид несовершенных грибов) в чашке Петри

140 лет со дня рождения Александра Флеминга
(Марка, Гвинея-Бисау, 2021 год)
Изображена медаль Нобелевской премии, врученная Флемингу по физиологии и медицине в 1945 году.
(Марка, Гвинея-Бисау, 2021 год)
Изображена медаль Нобелевской премии, врученная Флемингу по физиологии и медицине в 1945 году.
Александр Флеминг на банкноте Шотландии

5 Фунтов Стерлингов 2009 г. (Аверс)

5 Фунтов Стерлингов 2009 г. (Реверс)
Аверс:
Узорный фон, справа и слева - нитчатый гриб зелёной плесени (Penicillium notatum), вызывающий гибель стафилококков в культуре клеток, под микроскопом.
Справа - микроскоп Александра Флеминга.
В центре - портрет Александра Флеминга.
Справа - микроскоп Александра Флеминга.
В центре - портрет Александра Флеминга.
Реверс:
Коренные жители острова архипелага Сент-Килда, Шотландия (St.Kilda), который были внесён в список объектов всемирного наследия ЮНЕСКО в Великобритании (и Шотландии) дважды: в 1986 и 2005 годах.

Архипелаг Сент-Килда на карте Великобритании
